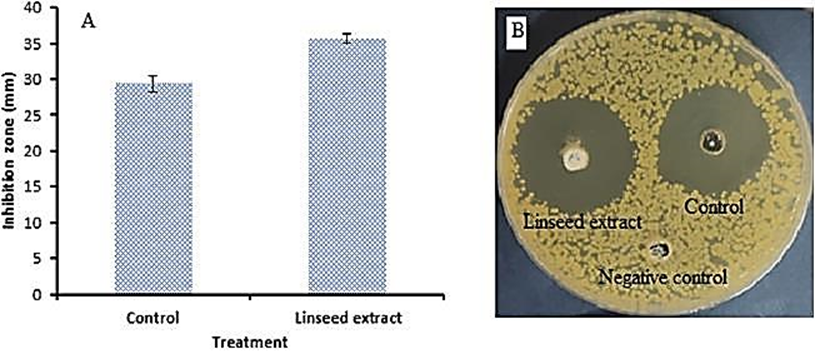

Evaluation of Biomedical Applications for Linseed Extract: Antimicrobial, Antioxidant, Anti-Diabetic, and Anti-Inflammatory Activities In Vitro
Abstract
1. Introduction
2. Materials and Methods
2.1. Source of Chemicals
2.2. Plant Sample and Test Microbe
2.3. Preparation of Linseed Extraction
2.4. Detection of Phenolic and Flavonoid Content of Linseed Extract by HPLC
2.5. Antibacterial Activity of Linseed Extract and Standard of Penolic and Flavonoid Compounds against Methicillin-Resistant S. aureus
2.6. Detection of Minimal Inhibitory Concentration (MIC) of Linseed Extract
2.7. Detection of Minimum Bactericidal Concentration (MBC) of Linseed Extract
2.8. Assessment of Linseed Extract against Antibiofilm of Methicillin-Resistant S. aureus
2.9. Antioxidant Potential of Linseed Extract via DPPH Method
2.10. Preparation of Erythrocyte Suspension and Hypotonicity Induced Haemolysis
2.11. Anti-Diabetic Activity of Linseed Extract via α-Glucosidase Inhibitory Assessment
2.12. Molecular Docking Methodology
2.13. Statistical Study
3. Results and Discussion
3.1. Phenolic and Flavonoid Characterization of Linseed
3.2. Antimicrobial Activity of Linseed Extract and Standard of Penolic and Flavonoid Compounds against MRSA
3.3. Antioxidant Activity of Linseed Extract
3.4. Anti-Diabetic Activity of Linseed Extract
3.5. Anti-Inflammatory Activity of Linseed Extract
3.6. Molecular Docking
4. Conclusions
Author Contributions
Funding
Institutional Review Board Statement
Informed Consent Statement
Data Availability Statement
Acknowledgments
Conflicts of Interest
References
- Herati, R.S.; Blumberg, E.E. Losing Ground: Multidrug-Resistant Bacteria in Solid-organ Transplantation. Curr. Opin. Infect. Dis. 2012, 25, 445–449. [Google Scholar] [CrossRef] [PubMed]
- Pitout, J.D. Infections with Extended-Spectrum Beta-Lactamase-Producing Enterobacteriaceae: Changing Epidemiology and Drug Treatment Choices. Drugs 2010, 3, 313–333. [Google Scholar] [CrossRef] [PubMed]
- Johnson, A.P. Antibiotic Resistance among Clinically Important Gram-positive Bacteria in the UK. J. Hosp. Infect. 1998, 40, 17–26. [Google Scholar] [CrossRef] [PubMed]
- Palla, A.H.; Khan, N.A.; Bashir, S.; Ur-Rehman, N.; Iqbal, J.; Gilani, A.H. Pharmacological Basis for the Medicinal Use of Linum usitatissimum (Flaxseed) in Infectious and Non-Infectious Diarrhea. J. Ethnopharmacol. 2015, 160, 61–68. [Google Scholar] [CrossRef]
- Abdel Ghany, T.M.; Ganash, M.; Alawlaqi, M.M.; Al-Rajhi, A.M. Antioxidant, antitumor, antimicrobial activities evaluation of Musa paradisiaca L. pseudostem exudate cultivated in Saudi Arabia. BioNanoScience 2019, 9, 172–178. [Google Scholar] [CrossRef]
- Abdelghany, T.M.; Al-Rajhi, A.M.; Yahya, R.; Bakri, M.M.; Al Abboud, M.A.; Yahya, R.; Qanash, H.; Bazaid, A.S.; Salem, S.S. Phytofabrication of Zinc Oxide Nanoparticles with Advanced Characterization and its Antioxidant, Anticancer, and Antimicrobial Activity against Pathogenic Microorganisms. Biomass Convers. Biorefinery 2023, 13, 417–430. [Google Scholar] [CrossRef]
- Al-Rajhi, A.M.H.; Abdel Ghany, T.M. Nanoemulsions of Some Edible Oils and Their Antimicrobial, Antioxidant, and Anti-hemolytic Activities. BioResources 2023, 18, 1465–1481. [Google Scholar] [CrossRef]
- Hammad, A.A.; Farrag, A.A.; Abdelghany, T.M.; El-Waseif, A.A.; Almawla, S.O.G. Correlation Study of Alcoholic Clove extract against Streptococcus agalactiae virulence factors isolated from Neonatal patients. Res. J. Pharm. Technol. 2022, 15, 3159–3164. [Google Scholar] [CrossRef]
- Jabir, M.S.; Sulaiman, G.M.; Taqi, Z.J.; Dong Li, D. Iraqi Propolis Increases Degradation of IL-1β and NLRC4 by Autophagy Following Pseudomonas aeruginosa Infection. Microbes Infect. 2018, 20, 89–100. [Google Scholar] [CrossRef]
- Ahmed, O.H.; Ezghayer, M.A.; Jabir, M.S.; Tawfeeq, M.F. Cytotoxic Activity of Methanolic Extract of Nerium oleander Naturally Grown in Iraq. J. Surv. Fish. Sci. 2023, 10, 2517–2524. [Google Scholar]
- Alyamani, A.A.; Al-Musawi, M.H.; Albukhaty, S.; Sulaiman, G.M.; Ibrahim, K.M.; Ahmed, E.M.; Jabir, M.S.; Al-Karagoly, H.; Aljahmany, A.A.; Mohammed, M.K.A. Electrospun Polycaprolactone/Chitosan Nanofibers Containing Cordia myxa Fruit Extract as Potential Biocompatible Antibacterial Wound Dressings. Molecules 2023, 28, 2501. [Google Scholar] [CrossRef]
- Christofidou-Solomidou, M.; Tyagi, S.; Tan, K.S.; Hagan, S.; Pietrofesa, R.; Dukes, F.; Arguiri, E.; Heitjan, D.F.; Solomides, C.C.; Cengel, K.A. Dietary Flaxseed Administered Post Thoracic Radiation Treatment Improves Survival and Mitigates Radiation-induced Pneumonopathy in Mice. BMC Cancer 2011, 11, 269. [Google Scholar] [CrossRef] [PubMed]
- Zuk, M.; Kulma, A.; Dymińska, L.; Szołtysek, K.; Prescha, A.; Hanuza, J.; Szopa, J. Flavonoid Engineering of Flax Potentiate its Biotechnological Application. BMC Biotechnol. 2011, 11, 10. [Google Scholar] [CrossRef]
- Akl, E.M.; Mohamed, S.S.; Hashem, A.I.; Fakhriya, S.T. Biological Activities of Phenolic Compounds Extracted from Flaxseed Meal. Bull. Natl. Res. Centre 2020, 44, 27. [Google Scholar] [CrossRef]
- Zuk, M.; Dorotkiewicz-Jach, A.; Drulis-Kawa, Z.; Arendt, M.; Kulma, A.; Szopa, J. Bactericidal Activities of GM Flax Seedcake Extract on Pathogenic Bacteria Clinical Strains. BMC Biotechnol. 2014, 14, 70. [Google Scholar] [CrossRef] [PubMed]
- Nakhlawy, F.S. Inheritance of Oil Content, Unsaturated Fatty Acid Composition and Iodine Number of Oil in Flax. Menoufia J. Agric. Res. 1996, 20, 483–492. [Google Scholar]
- Abdelghany, T.M. Eco-friendly and Safe Role of Juniperus procera in Controlling of Fungal Growth and Secondary Metabolites. J. Plant Pathol. Microbiol. 2014, 5, 231. [Google Scholar] [CrossRef]
- Abbas, S.H.; Mohammed, A.T. Antibacterial Activity of Flaxseeds Extracts on Streptococcus mutans: In Vitro Study. J. Res. Med. Dent. Sci. 2022, 10, 239–244. [Google Scholar]
- Ma, Q.; Li, Y.; Li, P.; Wang, M.; Wang, J.; Tang, Z.; Wang, T.; Luo, L.; Wang, C.; Wang, T.; et al. Research Progress in the Relationship between Type 2 Diabetes Mellitus and Intestinal Flora. Biomed. Pharmacother. 2019, 117, 109138. [Google Scholar] [CrossRef]
- Mechchate, H.; Es-safi, I.; Conte, R.; Hano, C.; Amaghnouje, A.; Jawhari, F.Z.; Radouane, N.; Bencheikh, N.; Grafov, A.; Bousta, D. In Vivo and In Vitro Antidiabetic and Anti-Inflammatory Properties of Flax (Linum usitatissimum L.) Seed Polyphenols. Nutrients 2021, 13, 2759. [Google Scholar] [CrossRef]
- Haroon, M.; Iqbal, M.J.; Hassan, W.; Ali, S.; Ahmed, H.; Hassan, S.U. Evaluation of Methanolic Crude Extract of Linum usitatissimum for the Removal of Biofilm in Diabetic Foot Isolates. Braz. J. Biol. 2021, 6, e245807. [Google Scholar] [CrossRef]
- Rafieian-Kopaei, M.; Shakiba, A.; Sedighi, M.; Bahmani, M. The Analgesic and Anti-Inflammatory Activity of Linum usitatissimum in Balb/c Mice. Evid.-Based Complement. Altern. Med. 2017, 22, 892–896. [Google Scholar] [CrossRef] [PubMed]
- Mohamed, R.R.; Basuny, A.M.; Sayed, R.R. Evaluation of the Effectiveness of Flaxseed on Type 2 Geriatric Diabetics. NILES J. Geriatr. Gerontol. 2023, 6, 99–113. [Google Scholar] [CrossRef]
- Elsayed, S.H.; Fares, N.H.; Elsharkawy, S.H.; Mahmoud, Y.I. Flaxseed Lignans Alleviates Isoproterenol-Induced Cardiac Hypertrophy by Regulating Myocardial Remodeling and Oxidative Stress. Ultrastruct. Pathol. 2023, 47, 122–129. [Google Scholar] [CrossRef]
- Qanash, H.; Alotaibi, K.; Aldarhami, A.; Bazaid, A.S.; Ganash, M.; Saeedi, N.H.; Ghany, T.A. Effectiveness of Oil-Based Nanoemulsions with Molecular Docking of its Antimicrobial Potential. BioResources 2023, 18, 1554–1576. [Google Scholar] [CrossRef]
- Maden, S.F.; Sezer, S.; Acuner, S.E. Fundamentals of Molecular Docking and Comparative Analysis of Protein–Small-Molecule Docking Approaches. In Molecular Docking-Recent Advances; IntechOpen: London, UK, 2023. [Google Scholar] [CrossRef]
- Al-Rajhi, A.M.H.; Qanash, H.; Almuhayawi, M.S.; Al Jaouni, S.K.; Bakri, M.M.; Ganash, M.; Salama, H.M.; Selim, S.; Abdelghany, T.M. Molecular Interaction Studies and Phytochemical Characterization of Mentha pulegium L. Constituents with Multiple Biological Utilities as Antioxidant, Antimicrobial, Anticancer and Anti-Hemolytic Agents. Molecules 2022, 27, 4824. [Google Scholar] [CrossRef] [PubMed]
- Qanash, H.; Yahya, R.; Bakri, M.M.; Bazaid, A.S.; Qanash, S.; Shater, A.F.; Abdelghany, T.M. Anticancer, Antioxidant, Antiviral and Antimicrobial Activities of Kei Apple (Dovyalis caffra) Fruit. Sci. Rep. 2022, 12, 5914. [Google Scholar] [CrossRef]
- French, G.L. Bactericidal Agents in the Treatment of MRSA Infections—The Potential Role of Daptomycin. J. Antimicrob. Chemother. 2006, 58, 1107. [Google Scholar] [CrossRef]
- Antunes, A.L.S.; Trentin, D.S.; Bonfanti, J.W.; Pinto, C.C.F.; Perez, L.R.R.; Macedo, A.J.; Barth, A.L. Application of A Feasible Method for Determination of Biofilm Antimicrobial Susceptibility in Staphylococci. Apmis 2010, 118, 873–877. [Google Scholar] [CrossRef]
- Mohammed, M.K.; Mohammad, M.R.; Jabir, M.S.; Ahmed, D.S. Functionalization, Characterization, and Antibacterial Activity of Single Wall and Multi Wall Carbon Nanotubes. In IOP Conference Series: Materials Science and Engineering; IOP Publishing: Bristol, UK, 2020; Volume 757, p. 012028. [Google Scholar] [CrossRef]
- Abdelghany, T.M.; Al-Rajhi, A.M.; Almuhayawi, M.S.; Abada, E.; Al Abboud, M.A.; Moawad, H.; Yahya, R.; Selim, S. Green Fabrication of Nanocomposite Doped with Selenium Nanoparticle–Based Starch and Glycogen with its Therapeutic Activity: Antimicrobial, Antioxidant, and Anti-inflammatory In Vitro. Biomass Convers. Biorefinery 2023, 13, 431–443. [Google Scholar] [CrossRef]
- Anosike, C.A.; Obidoa, O.; Ezeanyika, L.U. Membrane Stabilization as A Mechanism of the Anti-inflammatory Activity of Methanol Extract of Garden Egg (Solanum aethiopicum). DARU J. Pharm. Sci. 2012, 20, 76. [Google Scholar] [CrossRef]
- Pistia-Brueggeman, G.; Hollingsworth, R.I. A Preparation and Screening Strategy for Glycosidase Inhibitors. Tetrahedron 2001, 57, 8773–8778. [Google Scholar] [CrossRef]
- Yaqoob, N.; Munir, H.; Aslam, F.; Naseer, R.; Kamal, S.; Hussain, S.; Iqbal, M. Antioxidant Potential and Phenolic Contents of Various Flaxseed Cultivars from Different Agro-Industrial Regions. Pol. J. Environ. Stud. 2021, 30, 4325. [Google Scholar] [CrossRef]
- Al-Rajhi, A.M.H.; Yahya, R.; Abdelghany, T.M.; Fareid, M.A.; Mohamed, A.M.; Amin, B.H.; Masrahi, A.S. Anticancer, Anticoagulant, Antioxidant and Antimicrobial Activities of Thevetia peruviana Latex with Molecular Docking of Antimicrobial and Anticancer Activities. Molecules 2022, 27, 3165. [Google Scholar] [CrossRef] [PubMed]
- Yahya, R.; Al-Rajhi, A.M.H.; Alzaid, S.Z.; Al Abboud, M.A.; Almuhayawi, M.S.; Al Jaouni, S.K.; Selim, S.; Ismail, K.S.; Abdelghany, T.M. Molecular Docking and Efficacy of Aloe vera Gel Based on Chitosan Nanoparticles Against Helicobacter pylori and Its Antioxidant and Anti-Inflammatory Activities. Polymers 2022, 14, 2994. [Google Scholar] [CrossRef]
- Upadhyay, A.; Upadhyaya, I.; Kollanoor-Johny, A.; Baskaran, S.A.; Mooyottu, S.; Karumathil, D.; Venkitanarayanan, K. Inactivation of Listeria monocytogenes on Frankfurters by Plant-Derived Antimicrobials Alone or in Combination with Hydrogen Peroxide. Int. J. Food Microbiol. 2013, 163, 114–118. [Google Scholar] [CrossRef]
- Son, H.J.; Song, K.B. Antimicrobial Activity of Flaxseed Meal Extract Against Escherichia coli O157:H7 and Staphylococcus aureus Inoculated on Red Mustard. J. Microbiol. Biotechnol. 2017, 27, 67–71. [Google Scholar] [CrossRef]
- Sultana, U.; Zaidi, S.A.; Iqbal, N.; Quraishi, F.; Khan, M.A.; Baloch, F.A. Antibacterial Activity of Flax Seeds Extract Rinse against Streptococcus mutans Colonies. J. Pharm. Res. Int. 2022, 34, 19–24. [Google Scholar] [CrossRef]
- Bindu, I.; Jayachandran, V.P.; Elcey, C.D. Evaluation of Antistaphylococcal Activity of Ellagic Acid Extracted from Punica granatum Fruit Peel on MRSA. Int. J. Curr. Microbiol. Appl. Sci. 2016, 5, 245–253. [Google Scholar] [CrossRef]
- Salaheen, S.; Peng, M.; Joo, J.; Teramoto, H.; Biswas, D. Eradication and Sensitization of Methicillin Resistant Staphylococcus aureus to Methicillin with Bioactive Extracts of Berry Pomace. Front. Microbiol. 2017, 8, 253. [Google Scholar] [CrossRef] [PubMed]
- Kot, B.; Wierzchowska, K.; Grużewska, A.; Lohinau, D. The Effects of Selected Phytochemicals on Biofilm Formed by Five Methicillin-Resistant Staphylococcus aureus. Nat. Prod. Res. 2018, 32, 1299–1302. [Google Scholar] [CrossRef] [PubMed]
- Fan, R. Antimicrobial Activities of Chlorogenic Acid and 13 Main Metabolites in vitro. Chin. Tradit. Herb. Drugs 2020, 6239–6245. [Google Scholar]
- Noreen, S.; Tufail, T.; Bader Ul Ain, H.; Ali, A.; Aadil, R.M.; Nemat, A.; Manzoor, M.F. Antioxidant Activity and Phytochemical Analysis of Fennel Seeds and Flaxseed. Food Sci. Nutr. 2023, 11, 1309–1317. [Google Scholar] [CrossRef] [PubMed]
- Al-Ahmad, B.M.; Kashmoola, M.A.; Jabbar, O.A.; Mokhtar, K.I.; Mohamad, N.; Rahim, R.A.; Shaban, M.N. Histopathological Changes of the Flaxseed Extract on Skin Wound Healing in Diabetic Rabbits. Open Access Maced. J. Med. Sci. 2020, 8, 881–892. [Google Scholar] [CrossRef]
- Morsi, E.A.; Ahmed, H.O.; Abdel-Hady, H.; El-Sayed, M.; Shemis, M.A. GC-Analysis, and Antioxidant, Anti-Inflammatory, and Anticancer Activities of Some Extracts and Fractions of Linum usitatissimum. Curr. Bioact. Compd. 2020, 16, 1306–1318. [Google Scholar] [CrossRef]
- Al-Rajhi, A.M.H.; Qanash, H.; Bazaid, A.; Binsaleh, N.K.; Abdelghany, T.M. Pharmacological Evaluation of Acacia nilotica Flowers Extract against Helicobacter pylori, Human Hepatocellular Carcinoma In Vitro and In Silico. J. Funct. Biomater. 2023, 14, 237. [Google Scholar] [CrossRef]
- Qanash, H.; Bazaid, A.S.; Aldarhami, A.; Alharbi, B.; Almashjary, M.N.; Hazzazi, M.S.; Felemban, H.R.; Abdelghany, T.M. Phytochemical Characterization and Efficacy of Artemisia judaica Extract Loaded Chitosan Nanoparticles as Inhibitors of Cancer Proliferation and Microbial Growth. Polymers 2023, 15, 391. [Google Scholar] [CrossRef]

| Constituent Name | Retention Time | Area | Area (%) | Concentration (µg/mL) |
|---|---|---|---|---|
| Unknown | 2.55 | 58.50 | 8.05 | Undetected |
| Unknown | 2.65 | 217.16 | 29.90 | Undetected |
| Gallic acid | 3.35 | 33.41 | 4.60 | 155.10 |
| Chlorogenic acid | 4.21 | 262.44 | 36.14 | 1932.20 |
| Catechin | 4.78 | 6.60 | 0.91 | 87.85 |
| Methyl gallate | 5.61 | 96.88 | 13.34 | 284.31 |
| Caffeic acid | 6.06 | 7.93 | 1.09 | 32.78 |
| Syringic acid | 6.61 | 0.00 | 0.00 | 0.00 |
| Pyrocatechol | 6.78 | 0.00 | 0.00 | 0.00 |
| Rutin | 8.11 | 5.26 | 0.72 | 32.81 |
| Ellagic acid | 8.79 | 12.13 | 1.67 | 120.86 |
| Coumaric acid | 9.30 | 10.03 | 1.38 | 17.02 |
| Vanillin | 9.79 | 6.99 | 0.96 | 16.45 |
| Ferulic acid | 10.30 | 0.00 | 0.00 | 0.00 |
| Naringenin | 10.54 | 0.00 | 0.00 | 0.00 |
| Daidzein | 12.35 | 0.00 | 0.00 | 0.00 |
| Querectin | 12.85 | 0.00 | 0.00 | 0.00 |
| Cinnamic acid | 14.17 | 8.93 | 1.23 | 8.84 |
| Apigenin | 14.66 | 0.00 | 0.00 | 0.00 |
| Kaempferol | 15.17 | 0.00 | 0.00 | 0.00 |
| Hesperetin | 15.75 | 0.00 | 0.00 | 0.00 |
| Compound | Inhibition Zone (mm) |
|---|---|
| Gallic acid | 15.17 ± 0.29 |
| Chlorogenic acid | 17.67 ± 0.58 |
| Catechin | 12.84 ± 1.04 |
| Methyl gallate | 15.33 ± 1.15 |
| Caffeic acid | 14.83 ± 1.04 |
| Rutin | 15.17 ± 0.76 |
| Ellagic acid | 17.50 ± 0.87 |
| Coumaric acid | 10.67 ± 1.15 |
| Vanillin | 0.0 ± 0.00 |
| Concentration µg/mL | DPPH Scavenging % | |
|---|---|---|
| Linseed Extract | Ascorbic Acid | |
| Control | 0.0 ± 0.00 | 0.0 ± 0.00 |
| 1.95 | 27.5 ± 0.004 | 40.2 ± 0.007 |
| 3.90 | 35.0 ± 0.002 | 44.3 ± 0.002 |
| 7.81 | 39.1 ± 0.004 | 54.7 ± 0.003 |
| 15.63 | 45.7 ± 0.005 | 62.6 ± 0.005 |
| 31.25 | 52.8 ± 0.003 | 69.6 ± 0.004 |
| 62.50 | 60.3 ± 0.004 | 76.4 ± 0.006 |
| 125 | 68.1 ± 0.002 | 84.9 ± 0.006 |
| 250 | 74.6 ± 0.006 | 91.1 ± 0.005 |
| 500 | 82.1 ± 0.001 | 92.9 ± 0.004 |
| 1000 | 89.9 ± 0.006 | 95.5 ± 0.002 |
| IC50 | 20.8 µg/mL | 4.81 µg/mL |
| mol | rseq | mseq | S | rmsd_refine | E_conf | E_place | E_score1 | E_refine | E_score2 |
|---|---|---|---|---|---|---|---|---|---|
| Chlorogenic acid | 1 | 1 | −6.26841 | 1.0561086 | 0.14604893 | −50.8947 | −14.5724 | −31.1293 | −6.26841 |
| Chlorogenic acid | 1 | 1 | −5.89129 | 1.9759387 | −2.8599455 | −69.8904 | −14.2878 | −30.7783 | −5.89129 |
| Chlorogenic acid | 1 | 1 | −5.83516 | 2.193141 | −0.15038154 | −66.5634 | −15.248 | −29.6946 | −5.83516 |
| Chlorogenic acid | 1 | 1 | −5.71879 | 2.1018384 | −1.6470002 | −75.9115 | −14.7519 | −29.2169 | −5.71879 |
| Chlorogenic acid | 1 | 1 | −5.71228 | 1.7728372 | −5.547338 | −74.0203 | −16.8466 | −28.7861 | −5.71228 |
| Mol | Ligand | Receptor | Interaction | Distance | E (kcal/mol) |
|---|---|---|---|---|---|
| Chlorogenic acid | O 39 | O PRO 38 (B) | H-donor | 3.16 | −1.6 |
| O 19 | N LEU 3 (B) | H-acceptor | 3.11 | −1.6 | |
| O 22 | NZ LYS 195 (B) | H-acceptor | 2.87 | −2.8 | |
| O 23 | NZ LYS 2 (B) | H-acceptor | 2.87 | −2.3 |
Disclaimer/Publisher’s Note: The statements, opinions and data contained in all publications are solely those of the individual author(s) and contributor(s) and not of MDPI and/or the editor(s). MDPI and/or the editor(s) disclaim responsibility for any injury to people or property resulting from any ideas, methods, instructions or products referred to in the content. |
© 2023 by the authors. Licensee MDPI, Basel, Switzerland. This article is an open access article distributed under the terms and conditions of the Creative Commons Attribution (CC BY) license (https://creativecommons.org/licenses/by/4.0/).
Share and Cite
Alawlaqi, M.M.; Al-Rajhi, A.M.H.; Abdelghany, T.M.; Ganash, M.; Moawad, H. Evaluation of Biomedical Applications for Linseed Extract: Antimicrobial, Antioxidant, Anti-Diabetic, and Anti-Inflammatory Activities In Vitro. J. Funct. Biomater. 2023, 14, 300. https://doi.org/10.3390/jfb14060300
Alawlaqi MM, Al-Rajhi AMH, Abdelghany TM, Ganash M, Moawad H. Evaluation of Biomedical Applications for Linseed Extract: Antimicrobial, Antioxidant, Anti-Diabetic, and Anti-Inflammatory Activities In Vitro. Journal of Functional Biomaterials. 2023; 14(6):300. https://doi.org/10.3390/jfb14060300
Chicago/Turabian StyleAlawlaqi, Mohamed M., Aisha M. H. Al-Rajhi, Tarek M. Abdelghany, Magdah Ganash, and Hanan Moawad. 2023. "Evaluation of Biomedical Applications for Linseed Extract: Antimicrobial, Antioxidant, Anti-Diabetic, and Anti-Inflammatory Activities In Vitro" Journal of Functional Biomaterials 14, no. 6: 300. https://doi.org/10.3390/jfb14060300
APA StyleAlawlaqi, M. M., Al-Rajhi, A. M. H., Abdelghany, T. M., Ganash, M., & Moawad, H. (2023). Evaluation of Biomedical Applications for Linseed Extract: Antimicrobial, Antioxidant, Anti-Diabetic, and Anti-Inflammatory Activities In Vitro. Journal of Functional Biomaterials, 14(6), 300. https://doi.org/10.3390/jfb14060300

